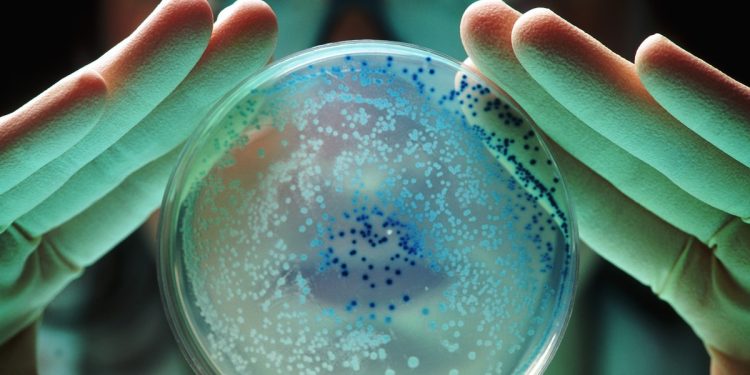
Mortes por superbactérias resistentes a antibióticos podem crescer 60% no mundo até 2050, diz estudo

Um estudo financiado pelo governo do Reino Unido mostra que, sem uma ação coordenada, o aumento das taxas de resistência antimicrobiana (RAM, em inglês) pode levar a perdas anuais globais de US$ 1,7 trilhão (R$ 9 trilhões) no PIB ao longo do próximo quarto de século.
A pesquisa, realizada pelo Center for Global Development e divulgada pelo The Guardian, constatou que as economias dos EUA, Reino Unido e União Europeia (UE) estariam entre as mais afetadas, o que levou a acusações de que os recentes cortes drásticos de verbas no combate a RAM em países de baixa e média renda são contraproducentes.
window._taboola = window._taboola || [];
_taboola.push({
mode: ‘organic-thumbs-feed-01-stream’,
container: ‘taboola-mid-article-saiba-mais’,
placement: ‘Mid Article Saiba Mais’,
target_type: ‘mix’
});
Anthony McDonnell, principal autor da pesquisa e pesquisador de políticas do Centro para o Desenvolvimento Global, afirmou: “Quando conduzimos nossa pesquisa sobre os impactos econômicos da resistência antimicrobiana, prevíamos que as taxas de resistência continuariam a seguir as tendências históricas.
No entanto, ele explica que os cortes abruptos de verbas tanto dos EUA como de países europeus podem elevar as taxas de resistência das bactérias, em linha com o cenário mais pessimista da pesquisa.
“Mesmo os países que conseguiram manter as taxas de RAM sob controle não podem se dar ao luxo de ser complacentes. A menos que os programas de RAM sejam protegidos contra cortes na ajuda, as taxas de resistência em todo o mundo provavelmente aumentarão a uma taxa compatível com a dos países mais afetados.
“Isso resultaria em milhões de mortes a mais em todo o mundo, inclusive nos países do G7. Investir em tratamento para infecções bacterianas agora salvará vidas e gerará bilhões em retornos econômicos a longo prazo.”
Impacto econômico e sanitário
A pesquisa calculou o impacto econômico e sanitário da resistência de bactérias a antibióticos em 122 países e previu que, nesse cenário mais pessimista, até 2050, as perdas de PIB na China poderiam chegar a pouco menos de US$ 722 bilhões (R$ 4 trilhões) por ano, nos EUA, US$ 295,7 bilhões (R$ 1,6 trilhão), na UE, US$ 187 bilhões (R$ 1 trilhão), no Japão, US$ 65,7 bilhões (R$ 365 bilhões) e no Reino Unido, US$ 58,6 bilhões (R$ 325 bilhões).
De acordo com o Instituto de Métricas e Avaliação em Saúde (IHME), espera-se que as mortes por RAM aumentem 60% até 2050, com 1,34 milhão de pessoas nos EUA e 184 mil no Reino Unido morrendo a cada ano devido a bactérias resistentes a antibióticos, enquanto o número de pessoas que adoecem gravemente devido a bactérias resistentes a medicamentos também deve aumentar.
As superbactérias aumentam o número de internações hospitalares e levam a internações mais longas e intensivas, tratamentos de segunda linha mais caros e cuidados mais complexos, o que significa que o tratamento de infecções resistentes é aproximadamente duas vezes mais caro do que o daquelas para as quais os antibióticos são eficazes.
O estudo estima os custos globais de saúde com o tratamento a resistência antimicrobiana (RAM) poderia aumentar em pouco menos de US$ 176 bilhões (R$ 977 bilhões) por ano, enquanto no Reino Unido, aumentaria de US$ 900 milhões (R$ 5 bilhões) para US$ 3,7 bilhões (R$ 20,5 bilhões) e nos EUA, de US$ 15,5 bilhões (R$ 86 bilhões) para pouco menos de US$ 57 bilhões (R$ 316 bilhões).
Taxas mais altas de bactérias resistentes também reduziriam a força de trabalho do Reino Unido, UE e EUA em 0,8%, 0,6% e 0,4%, respectivamente, conclui o estudo.
Por outro lado, se os países investirem mais no combate às superbactérias – aumentando o acesso a novos antibióticos e ao tratamento de alta qualidade dessas infecções – a economia dos EUA cresceria US$ 156,2 bilhões (R$ 866 bilhões) por ano e a do Reino Unido, US$ 12 bilhões (R$ 66 bilhões) até 2050.
É preciso agir agora
“Hoje, a ameaça da RAM está aumentando e, sem uma ação imediata de todas as partes interessadas, os medicamentos aos quais temos acesso agora podem parar de funcionar, potencialmente fazendo com que uma simples infecção se torne mortal”, afirmou Mohsen Naghavi, professor de métricas de saúde do IHME.
Isso envolveria mudanças nas políticas dos governos dos EUA, da Europa e do Reino Unido, o desenvolvimento de novos medicamentos e a garantia de que todos entendessem que os antibióticos são ineficazes contra vírus, acrescentou.
Um porta-voz do governo do Reino Unido disse: “Nosso plano de saúde de 10 anos reconhece a resistência antimicrobiana (RAM) como uma grande ameaça e se compromete a combater urgentemente sua disseminação, inclusive por meio de novas vacinas.
“Fizemos progressos importantes – reduzindo o uso de antibióticos na carne e sendo pioneiros em um modelo de assinatura pioneiro no mundo para incentivar o desenvolvimento de novos tratamentos. Também continuamos a trabalhar em estreita colaboração com parceiros internacionais para influenciar os esforços globais para limitar a disseminação da RAM.”
–borderColorFollowMe: #4a4a4a;
–textColorFollowMe: #005880;
}